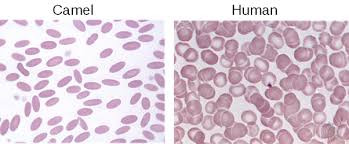

Mengapa unta makan banyak garam?
Ternyata unta sangat butuh garam untuk bertahan hidup.
Banyak video beredar di internet tentang pemberian garam pada unta; banyak netizen bertanya, “kenapa dikasih garam? Bukannya itu bahaya bagi mereka?” Jika kalian tahu, penggembala unta sering kali memberi makan unta garam dalam jumlah banyak sebelum melakukan aktivitas atau perjalanan yang jauh.
Hal ini dilakukan untuk kebaikan unta sendiri. Makan garam bagi unta tidak membahayakan; justru itu salah satu kebutuhan bagi mereka. Tapi kenapa?
Karena makan garam dalam jumlah banyak (bisa sampai lebih dari 100 liter) merangsang rasa haus sehingga membuat unta lebih banyak minum air. Selain membuat haus, manfaat lain adalah menjaga keseimbangan elektrolit, sehingga air yang diminum dapat disimpan dan bertahan lebih lama di dalam tubuhnya.
Berbeda dengan mamalia lain, sel darah merah unta berbentuk oval, bukan lingkaran. Bentuk ini memfasilitasi aliran sel darah merah saat dehidrasi dan membuat unta lebih tahan terhadap variasi osmotik tinggi tanpa pecah ketika minum air dalam jumlah besar.
Cara kerja sistemnya sangat khas dibanding mamalia lain. Unta dapat menahan kehilangan air sebesar 25%–30% dari berat badannya tanpa bahaya, sedangkan manusia atau hewan lain hanya dapat kehilangan sekitar 10%–15% sebelum mengalami gangguan sirkulasi atau masalah jantung.
Adaptasi ini sangat menguntungkan bagi unta, karena di lingkungan gurun hewan lain kesulitan bertahan hidup akibat sulitnya mencari sumber air dan makanan serta suhu yang ekstrem.
Perlu diketahui, pemberian garam pada unta juga dibatasi, dan diberi sesuai kebutuhan.